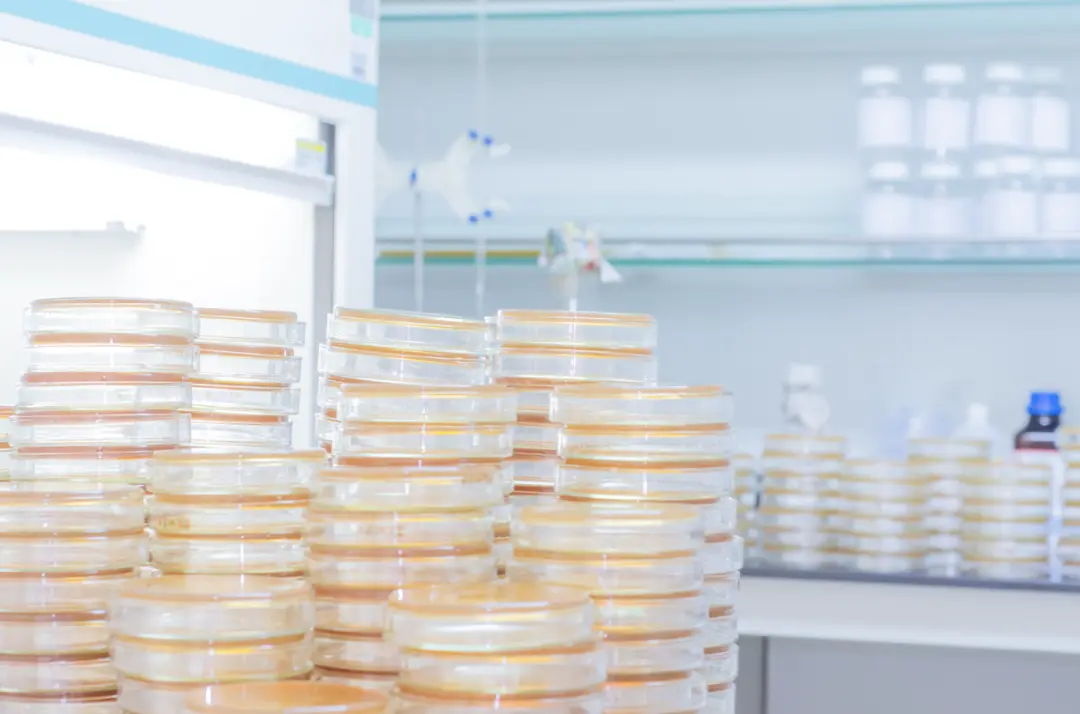
固体培养基

科研人必备技能!固体培养基的配制及储存注意事项
发布时间:2025-12-10 浏览次数:324
在微生物学研究中,培养基扮演着至关重要的角色,它为微生物的生长提供了一个可靠的环境,是其生长繁衍的营养基质。其中,不含凝固剂(如琼脂)、呈液体状态的培养基,我们称为液体培养基;呈固体状态的培养基为固体培养基。
向液体培养基中加入琼脂后制成的琼脂固体培养基,是我们在实验室中最常用的培养基之一,微生物在固体培养基的表面可形成肉眼可见的菌落。今天我们就来聊聊固体培养基的配制及储存注意事项。
固体培养基的配制
首先,我们需要根据实验目的选择适合的固体培养基配方。常见的固体培养基包括营养琼脂、LB培养基、麦康凯琼脂等。每种培养基都有其特定的应用场景,下面我们简单罗列了一些常用的固体培养基的配方及适用场景,供各位同学们参考。

选择好合适的培养基之后,我们再按照选定的配方准确称量所需的物质成分。精确的称量对于确保培养基的质量至关重要,但我们再称取肯定不能一把就称到准确的重量,通常来说,称取的克重可以大一丢丢,但绝对不能小,因为我们在加入到锥形瓶里时不可避免地会有一些粉末残留在称量盘上,所以稍微大一点没关系,但绝对不能小于所需克重,因为要确保微生物生长所需要的营养条件足够。
例如,要称取5g的成分的话,5.1g~5.2g之间的任何值都被视为符合要求。但对于一些微量成分,建议使用能够精确到0.001g或者更高精度的天平,并且尽可能减少操作误差,以保证微量成分的准确性。
以LB培养基为例,一般建议在一个称量盘中依次称量不同的成分,每称完一个成分就归零,向同一个称量盘内加入下一个成分进行称量。这还是因为我们在将粉末加入到锥形瓶里时,会有一些粉末残留在称量盘上。如果你用不同的称量盘分别称量那么误差就会变大,用同一个称量盘称量就能减小这部分误差。
称完后,我们一般先往锥形瓶的瓶底,加一点点水,再加入称好的粉末,避免粉末直接加到瓶内后会飞散。加入粉末后,摇匀,接着在定容至目标体积(需要注意的是,锥形瓶内的液体总体积不能超过容量的2/3)。然后在瓶口处盖上一张培养基封口膜,用橡皮筋固定住,再在外面覆盖上一层锡箔纸。

做完上面这些步骤我们就可以将配好的培养基放到高压灭菌锅内进行灭菌啦!
灭完菌,待培养基稍稍冷却之后,我们就可以准备倒平板了,具体的温度大约是50°C我们可以试着用手去摸瓶壁,摸着稍稍烫手即可。然后在超净台内,迅速倒入无菌的培养皿中,倒入的量不必精确,但要确保覆盖整个皿的底面,对于标准尺寸的培养皿来说,大约是20mL。
培养基冷却后,它就会凝固并变成不透明的,但完全凝固需要的时间一般会比较久。一般倒完平板后就放在超净台内,开抽风,不要开紫外,玻璃挡板留一小条缝,放置过夜。最好写一张便签贴,标明一下你在冷却平板,贴在超净台明显的位置,防止有些同学不知道,误用了你在晾平板的超净台,导致你的平板受到污染。
平板冷却凝固后,将培养皿倒置过来,以防止在琼脂表面凝结。然后将倒置的培养基装进大小合适的保鲜袋内,并在保鲜袋上标记好对应培养基的名称及配制日期,放入4℃冰箱保存即可。

本文由环凯转载自“实验老司机”公众号,版权归原作者(梨酱)所有,仅供学习参考,如有侵权请联系删除!
